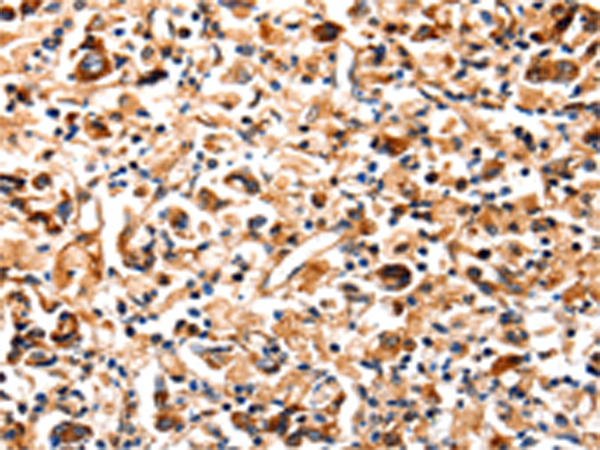
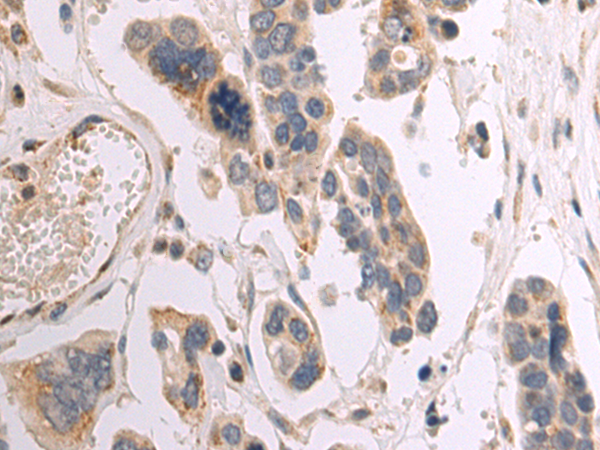

-
分类: 科研抗体货号: P07029别名: p65; NFKB3应用: WB,IHC反应种属: Human, Mouse
-
分类: 科研抗体货号: P07024别名: JIP, DPC4, MADH4, MYHRS应用: WB,IHC反应种属: Human, Mouse, Rat
-
分类: 科研抗体货号: P07047别名: CT19; IL-13R; IL13BP; CD213A2应用: IHC反应种属: Human
-
分类: 科研抗体货号: P07022别名: COX, COX8, VIII, COX8L, COX8-2, VIII-L应用: IHC反应种属: Human
-
分类: 科研抗体货号: P07065别名: K19; CK19; K1CS应用: WB,IHC反应种属: Human, Mouse, Rat
-
分类: 科研抗体货号: P07046别名: CD212; IL12RB; IL-12R-BETA1应用: IHC反应种属: Human
-
分类: 科研抗体货号: P07021别名:应用: IHC反应种属: Human
-
分类: 科研抗体货号: P07064别名: ABL; JTK7; p150; c-ABL; v-abl; CHDSKM; c-ABL1; BCR-ABL; bcr/abl应用: IHC反应种属: Human, Mouse
-
分类: 科研抗体货号: P07045别名: CRSDA应用: WB反应种属: Human
-
分类: 科研抗体货号: P07020别名: COXG; COX6B; MC4DN7; COXVIb1应用: WB,IHC反应种属: Human, Mouse

鄂公网安备42018502007531号
鄂公网安备42018502007531号

